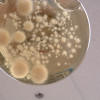

Le congélateur faisait du bruit...
Science | Affiché 605 fois | Publié le mercredi 28 juin 2023 à 10:04




Un préposé à l'entretien d'une université américaine a détruit accidentellement (lire: par manque de formation et/ou de jugement) des décennies de recherche universitaire américaine en éteignant un congélateur d'un laboratoire parce qu'il faisait trop de bruit.
Le Rensselaer Polytechnic Institute (RPI), situé à Troy, NY, poursuit l'employeur de l'agent d'entretien en invoquant une formation inadéquate. Selon le Times Union, l'université réclame plus d'un million de dollars de dommages et intérêts dans une plainte déposée au début du mois auprès de la Cour suprême de New York, dans le comté de Rensselaer. (traduction Deepl de l'article original)
Le reste de cette histoire à pleurer ici: https://www.theguardian.com/us-news/2023/jun/27/cleaner-college-research-freezer-rensselaer-polytechnic-institute
--
Photo: JA Majeau, 2006, INRS